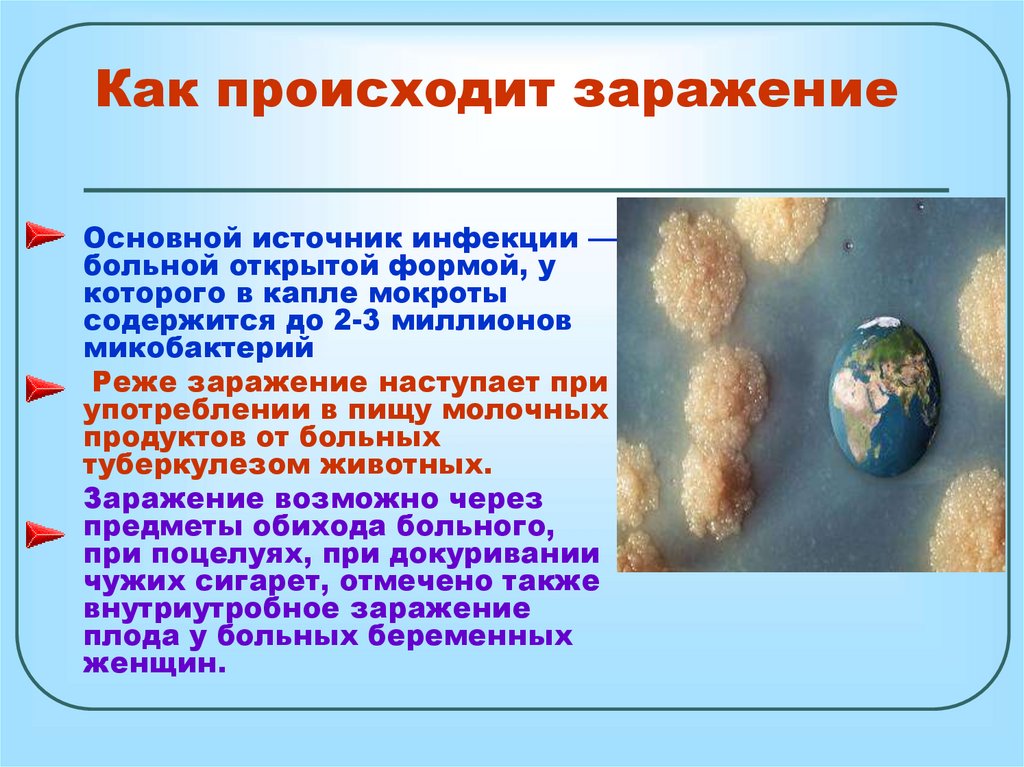

Similar presentations:
Туберкулез: угроза для всей планеты
1. Туберкулез: угроза для всей планеты
2.
Туберкулез - распространенное,инфекционное заболевание,
возбудителем которого является
микобактерия туберкулеза (МБТ).
Туберкулез - одна из самых
распространенных инфекций в мире
3.
Туберкулез - важнейшая социальная имедицинская проблема
Заболеваемость
Смертность
1980 - 1989 годы
с 1990 года
4.
основные клиническиепроявления туберкулеза
•длительный кашель
•слабость
•мокрота
•истощение, снижение веса
•кровохарканье
Абу Али Хусайн
Гиппократ
ибн Абдаллах
ибн Сина
•потливость
в
ночное
время
(460 - 377 г. до нашей эры)
(Авиценна)
(980 — 1037)
•боль в груди
5. Факторы, способствующие заболеванию туберкулезом:
неблагоприятные социальныеи экологические условия жизни;
неполноценное питание;
алкоголизм, курение, наркомания; —
снижение иммунитета;
стрессы;
наличие сопутствующих заболеваний
(диабета, язвенной болезни желудка или 12перстной кишки, заболеваний легких )
6. Роберт Кох (1843–1910)
Кто открыл возбудителя туберкулеза идоказал, что это не наследственное, а
инфекционное заболевание?
Немецкий бактериолог,
Возбудитель
удостоенный в 1905году
заболевания
–
Нобелевской премии
микобактерия
туберкулеза
была
по
физиологии и–медицине
открыта
за открытиеРобертом
и выделение
Кохом
в 1882
году,
возбудителя
туберкулеза.
ее назвали
“палочкой Коха”.
Роберт Кох
(1843–1910)
7.
Какими свойствамиобладает возбудитель туберкулеза?
В отличие
от других микробов,
При
температуре
+23
микобактерия
туберкулеза
градуса
бактерии
чрезвычайно живуча: отлично
остаются
себя чувствует и в земле,
жизнеспособными
до 7
и в снегу, устойчива
лет,
в высохшей
к воздействию
спирта, кислоты
мокроте
до 1 года,
на
и щелочи.- Погибнуть
она может
лишь под длительным
страницах
книг- до 6
воздействием
месяцев,
на прямых
одежде и
солнечных лучей, высоких
белье больного - до 4
температур и хлорсодержащих
месяцев.
веществ.
8. Как происходит заражение
Основной источник инфекции —больной открытой формой, у
которого в капле мокроты
содержится до 2-3 миллионов
микобактерий
Реже заражение наступает при
употреблении в пищу молочных
продуктов от больных
туберкулезом животных.
Заражение возможно через
предметы обихода больного,
при поцелуях, при докуривании
чужих сигарет, отмечено также
внутриутробное заражение
плода у больных беременных
женщин.
9.
пути заражениямикобактериями туберкулеза
1. Аэрогенный: (при вдыхании
воздуха)
• воздушно-капельный (при чихании и
кашле);
• воздушно-пылевой (в запыленных
помещениях, где находился больной).
2. Контактный (через предметы быта).
3. Пищевой (при употреблении в пищу
зараженных продуктов питания).
10.
Живые возбудителидлительное время могут
оставаться в организме,
и не всегда вызывают
заболевание
туберкулезом.
При внедрении в организм микобактерий
туберкулеза происходит инфицирование
(заражение), которое определяется у
детей пробой Манту. Такие люди
называются носителями туберкулезной
инфекции.
80 % взрослых жителей нашей планеты
являются постоянными носителями
микобактерий туберкулеза, т.е. они
инфицированы.
11.
Палочка Коха попадаетв человеческий организм
и приводит к изменению
состояния иммунной системы.
При активной форме
туберкулеза палочка Коха
быстро размножается в легких
больного и питается
человеческими тканями,
разрушая легкие, отравляя
организм человека
продуктами своей
жизнедеятельности. Вместе
с кровью и лимфой она может
распространяться по всему
организму.
12.
Туберкулез может поражатьразличные органы и ткани
человека: глаза, кости,
кожу, мочеполовую
систему, кишечник и т.д.
Тогда туберкулез
называется внелегочным,
но чаще всего встречается
туберкулез легких (83-88 %).
Цирротический
туберкулез легкого
Милиарный туберкулез
13.
Быстрая утомляемость и появлениеслабости
Снижение или отсутствие аппетита, потеря
в весе до 5-10 кг
Повышенная потливость, особенно по ночам
Появление одышки при небольших
физических нагрузках
Незначительное повышение температуры
до 37-37,5 градусов
Кашель или покашливание с выделением
мокроты, возможно с кровью
14.
При появлении первыхпризнаков заболевания
самолечением заниматься
нельзя, следует как можно
скорее обратиться
к врачу
за медицинской помощью
15. Диагностика
Если зараженный человекне заболевает сразу,
то он становится носителем
инфекции. Это можно
выявить только с помощью
пробы Манту.
Реакция на пробу Манту
считается положительной
при формировании
инфильтрата (папулы)
диаметром 5мм и более.
16. Диагностика
Для выявления заболеваниякроме пробы Манту проводят
флюорографическое
обследование (ФЛГ) органов
дыхания, которое позволяет
обнаружить ранние стадии
туберкулеза легких. Этот метод
диагностики совершенно
безвреден при одно - двукратном
исследовании в течение года,
доза рентгеновского облучения
очень мала.
17.
ДиагностикаПри выявлении
подозрения
на заболевание
Заподозрить
и выявить
туберкулезом все подозреваемые
туберкулезный
можно
направляются напроцесс
консультацию
к врачу-фтизиатру
.
следующими
основными
Чем меньше времени прошло с момента
методами:
выявления заражения
туберкулезом тем
выше проведении
вероятность того, что
заболевание
1.при
проб
Манту,
будет выявлено своевременно. Поэтому
2.фтизиатром
ФЛГ обследовании,
должны быть осмотрены все
на консультацию
лица в
3. направленные
при исследовании
мокроты
течение 10 - 14 дней с момента
на наличие
установлениябактерий.
у них инфицирования
туберкулезом.
18. Лечение.
Всех пациентов с выявленным туберкулезомможно вылечить, главное — делать это
правильно. Лечение должно быть
непрерывным и обязательно должно
проводиться одновременно
несколькими противотуберкулезными
препаратами. Каждое из 4-5 лекарств,
которые больной принимает
ежедневно в течение 6 месяцев,
по разному воздействует на палочки
Коха, и только совместное их
применение может достичь цели —
окончательно ее уничтожить.
19. Лечение.
Для качественного излечения однихпротивотуберкулезных лекарств недостаточно.
Больным также прописывают физиотерапию,
дыхательную гимнастику и препараты, поднимающие
иммунитет. Неправильное лечение превращает легко
излечимую форму болезни в трудно излечимый
лекарственно-устойчивый туберкулез. Хирургическое
лечение — удаление части легкого — применяется лишь
в запущенных случаях туберкулеза.
При отсутствии лечения смертность от активного
туберкулеза доходит до 50% в течение одного-двух лет.
В остальных случаях туберкулез переходит
в хроническую форму. Хронический больной живет
дольше, продолжая выделять микобактерии и заражать
окружающих.
20.
Чтобы уменьшить вероятность зараженияокружающих, человек, больной активным
туберкулезом, должен придерживаться
определенных правил:
прикрывать рот платком или рукой
и отворачиваться при кашле;
сжигать бумажные носовые платки
немедленно после употребления;
пользоваться отдельной посудой
и не позволять пользоваться ей другим.
21.
Как защитить себяот заражения туберкулезом?
Избегайте всего, что может ослабить защитные
силы Вашего организма. Берегите свое здоровье.
Соблюдайте режим труда, отдыха и питания.
Регулярно занимайтесь спортом. Больше
находитесь на свежем воздухе. Не курите, не
позволяйте курить другим в Вашем окружении.
Не злоупотребляйте алкоголем, наркотиками.
Чаще проветривайте помещения, где находитесь
(класс, квартира и др.). Систематически
проводите влажную уборку помещений.
Пользуйтесь индивидуальной посудой и
средствами гигиены. Обязательно соблюдайте
личную гигиену (мытье рук после возвращения с
улицы, из транспорта, из туалета и перед едой).
Держитесь подальше от кашляющих людей.
22.
Согласно рекомендациям ВсемирнойОрганизации Здравоохранения (ВОЗ),
иммунизацию вакциной БЦЖ считают одной
из наиболее важных мер по предупреждению
туберкулеза
23.
В России приказом Минздрава РФ от27.06.01 г . № 229 «О национальном
календаре профилактических прививок и
календаре профилактических прививок по
эпидемическим показаниям»
предусмотрена вакцинация против
туберкулеза новорожденных на 3-7 день,
первая ревакцинация в 7 лет
и вторая в 14 лет.
24.
Немедленнопосоветуйте ему
обратиться к врачу.
25.
Туберкулез сейчаспредставляет серьезную
опасность для
населения. Ежегодно
увеличивается
количество людей
заболевших
туберкулезом и
умерших от него.
Подумайте о сохранении
своего здоровья и
окружающих Вас людей.
26.
Посещайте флюорографический кабинетне реже 1 раза в год. Не препятствуйте
проведению противотуберкулезных
мероприятий и не отказывайтесь от
противотуберкулезных прививок.

medicine
medicine








